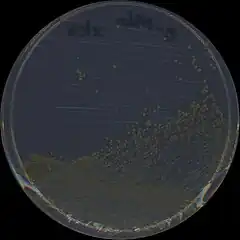
Description de cette image, également commentée ci-après

Sphingomonadaceae
| Domaine | Bacteria |
|---|---|
| Embranchement | Proteobacteria |
| Classe | Alphaproteobacteria |
| Ordre | Sphingomonadales |
Famille
Les Sphingomonadaceae sont une famille de protéobactéries à coloration Gram négative de l'ordre des Sphingomonadales.
Cette famille regroupe une quinzaine de genres, dont certaines espèces sont des bactéries phytopathogènes. Le genre type est Sphingomonas[2].
Une caractéristique importante des Sphingomonadaceae est la présence de sphingolipides dans la membrane externe de la paroi cellulaire[3]. Les cellules sont ovoïdes ou en forme de bâtonnet. Certaines sont également pléomorphes, c'est-à-dire que les cellules changent de forme au fil du temps. Certaines espèces sont phototrophes.
Les Sphingomonadaceae sont aussi connues par la capacité de certaines espèces à dégrader certains composés aromatiques. Cela rend ces bactéries intéressantes pour la dépollution de l'environnement[4].
Liste des genres
Selon Catalogue of Life (15 août 2014)[5] :
- genre Aminobacter
- genre Blastomonas
- genre Erythrobacter
- genre Erythromicrobium
- genre Novosphingobium
- genre Porphyrobacter
- genre Sandaracinobacter
- genre Sandarakinorhabdus
- genre Sphingobium
- genre Sphingomonas
- genre Sphingopyxis
- genre Sphingosinicella
- genre Zymomonas
Selon World Register of Marine Species (15 août 2014)[6] :
- genre Blastomonas Sly & Cahill, 1997
- genre Citromicrobium
- genre Lutibacterium
- genre Novosphingobium
- genre Sandaracinobacter
- genre Sandarakinorhabdus Gich & Overmann, 2006
- genre Sphingobium Takeuchi, Hamana & Hiraishi, 2001
- genre Sphingomonas
- genre Sphingopyxis
- genre Sphingosinicella
Liste des genres et non classés
Selon NCBI (15 août 2014)[7] :
- genre Blastomonas
- Blastomonas natatoria
- genre Citromicrobium
- Citromicrobium bathyomarinum
- non-classé Citromicrobium bathyomarinum JL354
- Citromicrobium bathyomarinum
- genre Hephaestia
- Hephaestia caeni
- genre Kaistobacter
- Kaistobacter terrae
- genre Lutibacterium
- Lutibacterium anuloederans
- genre Novosphingobium
- Novosphingobium acidiphilum
- non-classé Novosphingobium acidiphilum DSM 19966
- Novosphingobium aquaticum
- Novosphingobium aromaticivorans
- non-classé Novosphingobium aromaticivorans DSM 12444
- Novosphingobium barchaimii
- non-classé Novosphingobium barchaimii LL02
- Novosphingobium capsulatum
- non-classé Novosphingobium capsulatum NBRC 12533
- Novosphingobium fuchskuhlense
- Novosphingobium hassiacum
- Novosphingobium indicum
- Novosphingobium lentum
- non-classé Novosphingobium lentum NBRC 107847
- Novosphingobium lindaniclasticum
- non-classé Novosphingobium lindaniclasticum LE124
- Novosphingobium mathurense
- Novosphingobium naphthalenivorans
- non-classé Novosphingobium naphthalenivorans NBRC 102051
- Novosphingobium nitrogenifigens
- non-classé Novosphingobium nitrogenifigens DSM 19370
- Novosphingobium panipatense
- Novosphingobium pentaromativorans
- non-classé Novosphingobium pentaromativorans US6-1
- Novosphingobium resinovorum
- Novosphingobium rosa
- non-classé Novosphingobium rosa NBRC 15208
- Novosphingobium sediminicola
- Novosphingobium soli
- Novosphingobium stygium
- Novosphingobium subterraneum
- non-classé Novosphingobium subterraneum NBRC 16086
- Novosphingobium taihuense
- Novosphingobium tardaugens
- non-classé Novosphingobium tardaugens NBRC 16725
- Novosphingobium yangbajingensis
- Novosphingobium acidiphilum
- genre Parasphingopyxis
- Parasphingopyxis lamellibrachiae
- genre Polymorphobacter
- Polymorphobacter multimanifer
- genre Sandaracinobacter
- Sandaracinobacter sibiricus
- genre Sandarakinorhabdus
- Sandarakinorhabdus limnophila
- non-classé Sandarakinorhabdus limnophila DSM 17366
- Sandarakinorhabdus limnophila
- genre Sphingobium
- Sphingobium abikonense
- non-classé Sphingobium abikonense NBRC 16140
- Sphingobium amiense
- non-classé Sphingobium amiense NBRC 102518
- Sphingobium aromaticiconvertens
- Sphingobium baderi
- non-classé Sphingobium baderi LL03
- Sphingobium boeckii
- Sphingobium chinhatense
- non-classé Sphingobium chinhatense IP26
- Sphingobium chlorophenolicum
- non-classé Sphingobium chlorophenolicum L-1
- non-classé Sphingobium chlorophenolicum NBRC 16172
- Sphingobium chungbukense
- Sphingobium cloacae
- non-classé Sphingobium cloacae NBRC 102517
- Sphingobium cupriresistens
- Sphingobium czechense
- non-classé Sphingobium czechense LL01
- Sphingobium estrogenivorans
- Sphingobium faniae
- Sphingobium fontiphilum
- Sphingobium francense
- Sphingobium fuliginis
- non-classé Sphingobium fuliginis ATCC 27551
- Sphingobium herbicidovorans
- non-classé Sphingobium herbicidovorans NBRC 16415
- Sphingobium indicum
- non-classé Sphingobium indicum B90A
- Sphingobium japonicum
- non-classé Sphingobium japonicum BiD32
- non-classé Sphingobium japonicum UT26S
- Sphingobium jiangsuense
- Sphingobium lactosutens
- non-classé Sphingobium lactosutens DS20
- Sphingobium limneticum
- Sphingobium lucknowense
- non-classé Sphingobium lucknowense F2
- Sphingobium olei
- Sphingobium qiguonii
- Sphingobium quisquiliarum
- non-classé Sphingobium quisquiliarum P25
- Sphingobium rhizovicinum
- Sphingobium scionense
- Sphingobium suberifaciens
- non-classé Sphingomonas suberifaciens NBRC 15211
- Sphingobium sufflavum
- Sphingobium ummariense
- non-classé Sphingobium ummariense RL-3
- Sphingobium vermicomposti
- Sphingobium vulgare
- Sphingobium wenxiniae
- Sphingobium xenophagum
- non-classé Sphingobium xenophagum NBRC 107872
- non-classé Sphingobium xenophagum QYY
- Sphingobium yanoikuyae
- non-classé Sphingobium yanoikuyae ATCC 51230
- non-classé Sphingobium yanoikuyae XLDN2-5
- Sphingomonas agrestis
- Sphingobium sp.R5-6
- Sphingobium abikonense
- genre Sphingomicrobium
- Sphingomicrobium astaxanthinifaciens
- Sphingomicrobium lutaoense
- genre Sphingomonas
- Sphingomonas abaci
- Sphingomonas adhaesiva
- non-classé Sphingomonas adhaesiva NBRC 15099
- Sphingomonas aerolata
- Sphingomonas aestuarii
- non-classé Sphingomonas aestuarii DSM 19475
- Sphingomonas alpina
- Sphingomonas anadarae
- Sphingomonas aquatilis
- non-classé Sphingomonas aquatilis NBRC 16722
- Sphingomonas asaccharolytica
- non-classé Sphingomonas asaccharolytica NBRC 15499
- Sphingomonas astaxanthinifaciens
- non-classé Sphingomonas astaxanthinifaciens DSM 22298
- Sphingomonas aurantiaca
- Sphingomonas azotifigens
- non-classé Sphingomonas azotifigens NBRC 15497
- Sphingomonas azotofornans
- Sphingomonas bosoensis
- Sphingomonas canadensis
- Sphingomonas changbaiensis
- non-classé Sphingomonas changbaiensis NBRC 104936
- Sphingomonas cynarae
- Sphingomonas desiccabilis
- Sphingomonas dokdonensis
- Sphingomonas echinoides
- non-classé Sphingomonas echinoides ATCC 14820
- Sphingomonas elodea
- non-classé Sphingomonas elodea ATCC 31461
- Sphingomonas endophytica
- Sphingomonas faeni
- Sphingomonas fennica
- Sphingomonas formosensis
- Sphingomonas genosp 1
- Sphingomonas genosp 2
- Sphingomonas ginsenosidimutans
- Sphingomonas ginsenosidivorax
- Sphingomonas glacialis
- Sphingomonas haloaromaticamans
- Sphingomonas hankookensis
- Sphingomonas histidinilytica
- Sphingomonas humi
- Sphingomonas hunanensis
- Sphingomonas indica
- Sphingomonas insulae
- Sphingomonas japonica
- Sphingomonas jaspsi
- non-classé Sphingomonas jaspsi DSM 18422
- Sphingomonas jejuensis
- Sphingomonas jinjuensis
- Sphingomonas kaistensis
- Sphingomonas koreensis
- non-classé Sphingomonas koreensis NBRC 16723
- Sphingomonas kwangyangensis
- Sphingomonas kyungheensis
- Sphingomonas laterariae
- Sphingomonas leidyi
- Sphingomonas mali
- non-classé Sphingomonas mali NBRC 15500
- Sphingomonas mathurensis
- Sphingomonas melonis
- non-classé Sphingomonas melonis C3
- non-classé Sphingomonas melonis DAPP-PG 224
- non-classé Sphingomonas melonis FR1
- Sphingomonas molluscorum
- Sphingomonas mucosissima
- Sphingomonas oligophenolica
- Sphingomonas oryziterrae
- Sphingomonas panni
- Sphingomonas parapaucimobilis
- non-classé Sphingomonas parapaucimobilis NBRC 15100
- Sphingomonas paucimobilis
- non-classé Sphingomonas paucimobilis NBRC 13935
- Sphingomonas phyllosphaerae
- non-classé Sphingomonas phyllosphaerae 5.2
- non-classé Sphingomonas phyllosphaerae FA2
- Sphingomonas pituitosa
- non-classé Sphingomonas pituitosa NBRC 102491
- Sphingomonas polyaromaticivorans
- Sphingomonas pruni
- non-classé Sphingomonas pruni NBRC 15498
- Sphingomonas pseudosanguinis
- Sphingomonas rhizogenes
- Sphingomonas rosea
- Sphingomonas roseiflava
- Sphingomonas rubra
- Sphingomonas sanguinis
- non-classé Sphingomonas sanguinis NBRC 13937
- Sphingomonas sanxanigenens
- non-classé Sphingomonas sanxanigenens DSM 19645
- Sphingomonas soli
- non-classé Sphingomonas soli NBRC 100801
- Sphingomonas starnbergensis
- Sphingomonas swuensis
- Sphingomonas trueperi
- non-classé Sphingomonas trueperi NBRC 100456
- Sphingomonas ursincola
- Sphingomonas wittichii
- non-classé Sphingomonas wittichii DP58
- non-classé Sphingomonas wittichii RW1
- non-classé Sphingomonas wittichii TTN3
- non-classé Sphingomonas wittichii TTNP3
- Sphingomonas xinjiangensis
- Sphingomonas yabuuchiae
- Sphingomonas yunnanensis
- genre Sphingopyxis
- Sphingopyxis alaskensis
- non-classé Sphingopyxis alaskensis RB2256
- Sphingopyxis baekryungensis
- non-classé Sphingopyxis baekryungensis DSM 16222
- Sphingopyxis bauzanensis
- Sphingopyxis chilensis
- Sphingopyxis flavimaris
- Sphingopyxis ginsengisoli
- Sphingopyxis granuli
- non-classé Sphingopyxis granuli NBRC 100800
- Sphingopyxis indica
- Sphingopyxis italica
- Sphingopyxis litoris
- non-classé Sphingopyxis litoris DSM 22379
- Sphingopyxis macrogoltabida
- non-classé Sphingopyxis macrogoltabida NBRC 15033
- Sphingopyxis marina
- non-classé Sphingopyxis marina DSM 22363
- Sphingopyxis panaciterrae
- Sphingopyxis panaciterrulae
- Sphingopyxis rigui
- Sphingopyxis soli
- Sphingopyxis taejonensis
- Sphingopyxis terrae
- non-classé Sphingopyxis terrae NBRC 15098
- Sphingopyxis ummariensis
- Sphingopyxis witflariensis
- Sphingopyxis wooponensis
- Sphingopyxis alaskensis
- genre Sphingorhabdus
- Sphingorhabdus planktonica
- genre Sphingosinicella
- Sphingosinicella microcystinivorans
- Sphingosinicella soli
- Sphingosinicella vermicomposti
- Sphingosinicella xenopeptidilytica
- genre Stakelama
- Stakelama pacifica
- Stakelama sediminis
- genre Zymomonas
- Zymomonas mobilis
- sous-espèce Zymomonas mobilis subsp. francensis
- sous-espèce Zymomonas mobilis subsp. mobilis
- sous-espèce Zymomonas mobilis subsp. mobilis ATCC 10988
- sous-espèce Zymomonas mobilis subsp. mobilis ATCC 29191
- sous-espèce Zymomonas mobilis subsp. mobilis ATCC 31822
- sous-espèce Zymomonas mobilis subsp. mobilis IRMH52
- sous-espèce Zymomonas mobilis subsp. mobilis NCIMB 11163
- sous-espèce Zymomonas mobilis subsp. mobilis NRRL B-12526
- sous-espèce Zymomonas mobilis subsp. mobilis str. CP4 - NRRL B-14023
- sous-espèce Zymomonas mobilis subsp. mobilis ZM4 - ATCC 31821
- sous-espèce Zymomonas mobilis subsp. pomaceae
- sous-espèce Zymomonas mobilis subsp. pomaceae ATCC 29192
- Zymomonas mobilis
Notes et références
- ↑ (en) Yoshimasa Kosako, Eiko Yabuuchi, Takashi Naka et Nagatoshi Fujiwara, « Proposal of Sphingomonadaceae Fam. Nov., Consisting of Sphingomonas Yabuuchi et al. 1990, Erythrobacter Shiba and Shimidu 1982, Erythromicrobium Yurkov et al. 1994, Porphyrobacter Fuerst et al. 1993, Zymomonas Kluyver and van Niel 1936, and Sandaracinobacbacter Yurkov et al. 1997, with the Type Genus Sphingomonas Yabuuchi et al. 1990 », Microbiology and Immunology, vol. 44, no 7, , p. 563–575 (DOI 10.1111/j.1348-0421.2000.tb02535.x, lire en ligne, consulté le )
- ↑ (en) « Sphingomonadaceae », sur List of Prokaryotic names with Standing in Nomenclature (LPSN) (consulté le ).
- ↑ (en) Garrity, George M.; Brenner, Don J.; Krieg, Noel R.; Staley, James T., The Proteobacteria, Part C : The Alpha-, Beta-, Delta-, and Epsilonproteobacteria, New York, Springer, , 1388 p. (ISBN 978-0-387-24145-6, lire en ligne), « Bergey's Manual of Systematic Bacteriology, Volume Two: ».
- ↑ (en) David L. Balkwill, J. K. Fredrickson et M. F. Romine, The Prokaryotes, A Handbook of the Biology of Bacteria, t. 7, Proteobacteria: Delta and Epsilon Subclasses. Deeply Rooting Bacteria, , 1074 p. (ISBN 978-0-387-33493-6), « Sphingomonas and Related Genera ».
- ↑ Catalogue of Life Checklist, consulté le 15 août 2014.
- ↑ World Register of Marine Species, consulté le 15 août 2014.
- ↑ NCBI, consulté le 15 août 2014.
Liens externes
- (en) Catalogue of Life : Sphingomonadaceae (consulté le )
- (en) NCBI : Sphingomonadaceae (taxons inclus) (consulté le )
- (en) WoRMS : Sphingomonadaceae (+ liste genres + liste espèces) (consulté le )
- Portail de la microbiologie